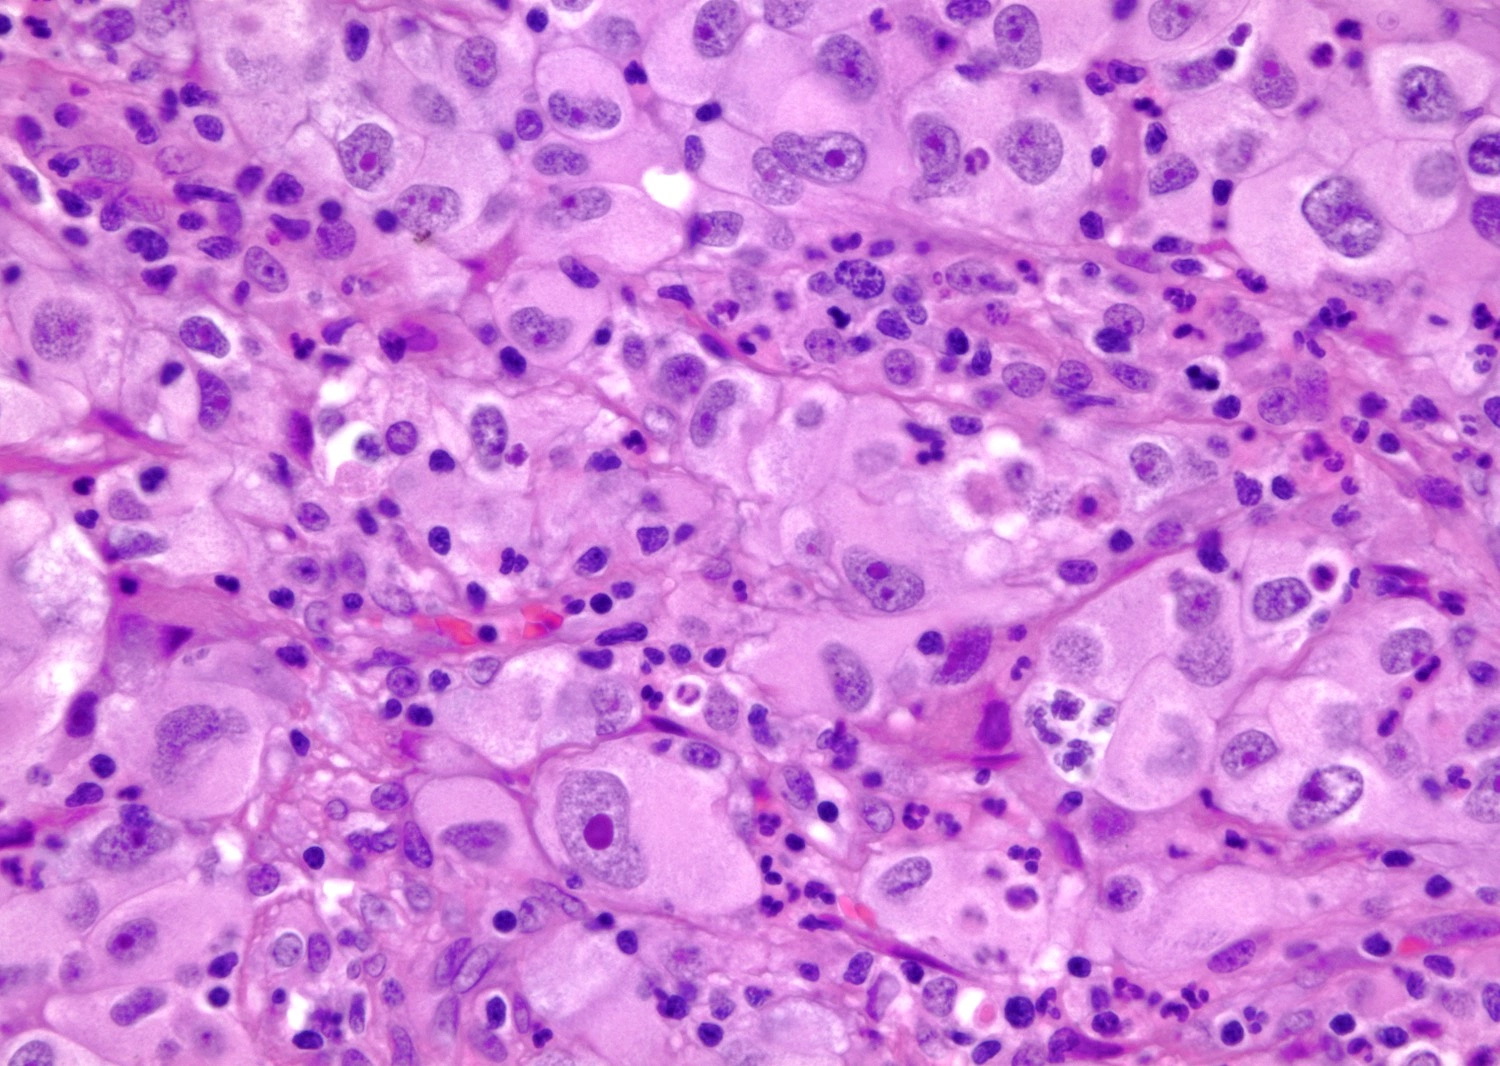

Рак почки, или почечно-клеточный карцином, делится на несколько стадий в зависимости от распространенности опухоли. На ранних стадиях опухоль может проявляться бессимптомно, в то время как на более поздних могут наблюдаться симптомы, такие как кровь в моче, боль в боку, потеря веса и повышенное артериальное давление. Диагностика включает УЗИ, КТ и биопсию, что позволяет определить стадию и характеристики опухоли.
Лечение рака почки зависит от стадии заболевания и может включать хирургическое вмешательство, иммунную терапию, таргетную терапию и химиотерапию. Прогноз зависит от раннего выявления заболевания; при обнаружении на I стадии 5-летняя выживаемость составляет более 90%, в то время как на IV стадии она значительно ниже. Регулярные медицинские обследования и внимание к симптомам играют ключевую роль в ранней диагностике и успешном лечении.
Общее представление о раке почки
Рак почки представляет собой серьезное онкологическое заболевание, при котором в одном или обоих почках образуется злокачественная опухоль. Данная болезнь может весьма быстро развиваться и вызывать образование метастазов.
Согласно международной классификации болезней (МКБ-10), рак почки обозначается кодом C64, где учитываются все злокачественные опухоли, кроме образования в лоханке.
На данный момент этот вид рака диагностируется примерно у 2% населения. В урологии он занимает третье место по частоте встречаемости, уступая только опухолям мочевого пузыря и простаты.
Наиболее часто заболевание наблюдается у мужчин старше 40 лет, при этом они сталкиваются с данным недугом в три раза чаще, чем женщины.
Факторы, способствующие развитию онкологических заболеваний, являются многообразными и нередко взаимосвязаны. Определить основной из них иногда бывает сложно, однако научные исследования показали, что на возникновение рака почки значительно влияют ослабление иммунной системы и механически-патогенные факторы, а также наследственная предрасположенность.
- гипертония;
- обмен веществ;
- ожирение;
- долгосрочное применение диуретиков;
- курение.
Риск развития заболевания также повышается у людей с мочекаменной болезнью, пиелонефритом и другими хроническими почечными нарушениями. Длительное проведение гемодиализа и постоянный прием обезболивающих и диуретиков также могут способствовать этому процессу.
Классификация рака почки
Данный вид опухоли характеризуется быстрым, неконтролируемым делением клеток, которые не выполняют специализированные функции. В результате их размножение происходит так быстро, что клетки не успевают освоить свою роль, что увеличивает их количество и распространение по кровеносной и лимфатической системам.
Новые опухолевые клетки разрушают здоровые ткани, на которых они растут, а продукты распада вызывают интоксикацию организма, что может привести к тяжелым осложнениям. Половина пациентов умирает именно от последствий этого заболевания.
Рак почки представляет собой многогранное заболевание, которое может проявляться различными симптомами, такими как кровь в моче, боли в пояснице, потеря веса, усталость и повышение температуры тела. На ранних стадиях болезнь может протекать бессимптомно, что затрудняет раннюю диагностику.
- На первой стадии образуется небольшая медленно растущая опухоль в тканях органа, которая еще не затрагивает лимфатическую систему и окружающие ткани.
- На второй стадии опухоль начинает увеличиваться и становится агрессивной, вовлекая в процесс соседние структуры.
- На третьей стадии размеры опухоли могут достигать 10 см, и клетки проникают в кровеносные и лимфатические сосуды, но не затрагивают другие органы.
- Четвертая стадия характеризуется крупной опухолью и быстрым метастазированием.
- 1 степень соответствует светлоклеточной опухоли с минимальными изменениями здоровых тканей;
- 2 степень обозначает почечно-клеточную опухоль средней дифференциации;
- 3 степень — это низкодифференцированная светлоклеточная опухоль;
- 4 степень — бластома с большой степенью отличия от нормальной ткани;
- X степень указывает на неопределенность степени дифференциации светлоклеточной опухоли.
Лечение рака почки зависит от стадии заболевания и может включать хирургическое вмешательство, иммунотерапию, таргетную терапию и химиотерапию. Раннее выявление рака почки и начатое лечение значительно увеличивают шансы на выздоровление. Регулярные медицинские осмотры и внимание к своему здоровью помогут снизить риски и улучшить качество жизни пациентов.
Выживаемость при раке почки
Выживаемость пациентов с раком почки существенно зависит от стадии заболевания. Как правило, большинство пациентов — люди старше 40 лет, часто страдающие от хронических заболеваний, которые ухудшают защитные функции организма. На первой стадии, как правило, существует высокая вероятность излечения: около 90% пациентов могут рассчитывать на пятилетнюю выживаемость после успешного лечения без рецидивов.
К сожалению, большинство обращений за медицинской помощью происходят на 3-4 стадиях, когда болезнь уже дала метастазы. В таких случаях только 10% пациентов могут надеяться на двухлетнюю выживаемость. Удаление почки также не всегда гарантирует защиту от рецидива.
Метастазы значительно снижают вероятность пятилетней выживаемости, сокращая ее до 9%.
Прогноз для пациентов на первой и второй стадиях достаточно оптимистичный, хотя он также зависит от своевременности обращения за медицинской помощью и выбранного метода лечения. Хотя в редких случаях народные методы лечения могут приносить результаты, чаще всего самолечение приводит к негативным последствиям. Операция дает значительно больше шансов на успешное выздоровление, чем альтернативные методы.
Наилучший прогноз будет у пациентов с хромофобным раком, и чуть хуже — у папиллярного типа. Наиболее неблагоприятные результаты характерны для традиционных форм.
Каждому пациенту необходимо пересмотреть свое отношение к образу жизни и диете, внимательно следя за состоянием здоровья. При приеме любых препаратов следует помнить о потенциальной нагрузке на оставшуюся почку, особенно если была проведена нефрэктомия.
Важно помнить, что раннее обнаружение заболевания и своевременное начало лечения могут значительно улучшить результаты. Регулярные медицинские обследования и контроль за состоянием здоровья могут помочь выявить рак на начальных стадиях. Кроме того, пациенты должны быть внимательны к симптомам, таким как кровянистые выделения в моче, боли в спине или боку, увеличение живота, которые могут указывать на проблемы с почками.
Существует ряд дополнительных методов лечения, включая таргетную терапию и иммунотерапию, которые могут быть рассмотрены для улучшения шансов на выживание, особенно в случае прогрессирующей болезни. Каждому пациенту рекомендуется обсудить все возможные варианты лечения с врачом-онкологом.
Наконец, поддержка со стороны близких, участие в группах по поддержке пациентов и психотерапия могут сыграть важную роль в эмоциональном благополучии и настройке на положительный исход лечения.
Прогноз при раке почки
Прогноз для пациентов с раком почки во многом зависит от их выдержки и строгости в соблюдении рекомендаций врачей.
Люди с гипертонией, диабетом и нарушениями сердечно-сосудистой системы должны регулярно проходить обследования у специалистов, чтобы избежать возможных осложнений.
Неконтролируемая гипертония может привести к повреждению сосудов почки и даже к ее отказу. Важно помнить, что каждый случай рака почки индивидуален, и общие показатели выживаемости могут не подойти всем пациентам.
Возраст, общее состояние здоровья и тип опухоли играют ключевую роль в шансах на успешное лечение или длительную ремиссию.
Следует учитывать, что показатели выживаемости зависят также от места проживания пациента, так как качество медицинских услуг и диагностики варьируется.
Современные подходы в лечении рака почки акцентируют внимание на минимизации травматизма. Это особенно актуально для пожилых и ослабленных пациентов. Предпочтение часто отдается менее инвазивным методам, таким как лапароскопия или криоабляция.
Для улучшения прогноза необходимо выявить наличие опухолевых тромбов в венах, так как это может снизить риск метастазирования. Важно вовремя диагностировать поражения лимфатических узлов и крупных сосудов.
Хотя многие аспекты развития рака почки до сих пор изучаются, в том числе механизмы спонтанных ремиссий, терапия с использованием таргетных препаратов, таких как Нексавар, показывает обнадеживающие результаты и может улучшить качество жизни пациентов.
Метастазирование рака почки
Раковые клетки из почек могут метастазировать несколькими путями:
- Инвазивный рост в соседние ткани, включая надпочечники — маленькие железы над почками;
- Лимфогенное распространение, при котором раковые клетки мигрируют через лимфатические сосуды;
- Гематогенное метастазирование, в ходе которого опухолевые клетки попадают в кровеносные сосуды и распространяются по всему организму, оседая в различных органах и формируя вторичные очаги.
Чаще всего метастазы из почек поражают легкие, печень, кости, головной мозг и надпочечники.
Диагностика рака почки
Определить наличие рака почки и его метастазов можно по результатам различных анализов:
- Общий анализ мочи — может показать наличие гемоглобина, а в редких случаях — злокачественные клетки;
- Общий анализ крови — может показать снижение количества эритроцитов из-за хронической анемии, но иногда количество эритроцитов увеличивается из-за секреции опухолью эритропоэтина;
- Биохимический анализ крови — может зафиксировать повышение уровня некоторых ферментов и кальция, что указывает на поражение костей.
Симптоматика заболеваний почек часто бывает недостаточно специфичной, что делает их диагностику затруднительной. При подозрении на опухоли почек необходимы дополнительные исследования. Для визуализации почечной ткани и выявления новообразований широко используют несколько методов:
- Компьютерная томография (КТ) — эффективный способ, позволяющий обнаружить опухоли, оценить их количество, размеры, расположение и возможное прорастание в окружающие ткани и сосуды.
- Магнитно-резонансная томография (МРТ) применяется реже, чем КТ, однако она хорошо визуализирует метастазы, особенно в мозге, и помогает оценить состояние кровеносной системы. Этот метод рекомендован пациентам, которым противопоказано КТ.
- Позитронно-эмиссионная томография с компьютерной томографией (ПЭТ-КТ) использует радиоактивно меченый сахар для выявления раковых клеток, активно потребляющих глюкозу. Это позволяет обнаруживать микрометастазы, которые другие исследования не фиксируют, и корректировать терапию при необходимости.
- Рентгенография используется для выявления метастазов в легких и костях.

Виды рака почки
Существуют различные типы рака почки, отличающиеся клеточным составом и характером роста.
Наиболее распространённым является почечно-клеточная карцинома — 85% случаев заболевания. Она развивается в проксимальных почечных канальцах, отвечающих за фильтрацию крови.
Гистология почечно-клеточного рака (увеличение 400х)
Уротелиальная карцинома, также известная как переходно-клеточная карцинома, составляет 5-10% случаев у взрослых. Этот тип рака начинается в области почечной лоханки.
Саркома почки встречается реже и возникает в соединительных тканях, окружающих орган. Ее лечение чаще всего хирургическое, однако риск рецидива велик.
У детей наиболее часто отсутствует опухоль Вильмса, которая требует совершенно иного подхода к лечению, включая химиотерапию и хирургическую операцию.
Лимфома может развиваться в обеих почках, а также ассоциироваться с другим увеличением лимфатических узлов. Иногда проявляется как отдельное образование, которое впоследствии затрагивает лимфатические узлы. При подозрении на лимфому врач может назначить биопсию и химиотерапию.
Проявления рака почки
Часто рак почки выявляется случайно во время рутинных исследований, таких как УЗИ или рентген. В начальной стадии рак может не проявляться симптомами. Первые признаки часто развиваются при вовлечении соседних тканей. К основным симптомам относятся:
- Кровь в моче (как видимая, так и диагностируемая в лаборатории);
- Боль в поясничной области;
- Образование, ощущаемое в области талии;
- Отёки, поднимающиеся до лодыжек;
- Увеличение артериального давления, плохо реагирующее на лечение;
- Снижение эритроцитов и анемия;
- Постоянная усталость и слабость;
- Потеря аппетита и, как следствие, потеря веса;
- Повышенная температура без явных инфекционных причин.
У мужчин могут возникнуть варикозные расширения вен в мошонке (варикоцеле), особенно если поражается правое яичко, что может указывать на наличие крупной опухоли. У многих пациентов симптомы могут отсутствовать до поздних стадий заболевания.
Если у вас есть подозрения на рак, важно незамедлительно обратиться к врачу.
Свяжитесь с нами!
Этапы рака почки
Стадии рака определяются по классической системе AJCC TNM, где учитываются размер опухоли, наличие метастазов и вовлечение лимфатических узлов.
На первой стадии размеры опухоли не превышают 7 см, отсутствуют метастазы и воспаление лимфоузлов. В настоящее время первая стадия делится на подкатегории IA (до 4 см) и IB (от 4 до 7 см).
На второй стадии опухоль превышает 7 см, но остается ограниченной почкой, при этом также имеется деление на IIA (до 10 см) и IIB (более 10 см).
Третья стадия возникает, когда опухоль распространилась за пределы почки: либо непосредственно вовлекая венозные структуры, либо дав метастазы в лимфатические узлы.
Четвёртая стадия включает наличие отдалённых метастазов или выход опухоли за фасцию Герота — эта стадия считается наиболее неблагоприятной.

Методы лечения рака почки
Лечение рака почки зависит от разных факторов, но в большинстве случаев используется хирургическое вмешательство как наиболее эффективный метод. Операция может быть полным удалением почки или резекцией (удалением части органа). Поскольку большинство случаев выявляются на ранней стадии, такая терапия оказывается успешной.
Прогноз после операции, как правило, хороший, даже в случае частичной резекции.
Химиотерапия и лучевая терапия применяются реже и чаще имеют менее эффективные результаты, поскольку опухоли в почках обычно хорошо сопротивляются этим методам. Тем не менее в некоторых случаях такие подходы могут существенным образом уменьшить размеры опухоли.
Существует Возможность использования других методов лечения. Например, таргетная терапия становится основным подходом при невозможности хирургического вмешательства, превращая неизлечимый рак в хроническую болезнь и значительно продлевая жизнь пациентов. Это подтверждают исследования, опубликованные в журнале «Онкоурология» в 2013 году.
Иммунотерапия также может быть использована, активируя иммунную систему для более эффективной борьбы с болезнью.
Каждый из этих методов представляет собой часть целостного подхода к лечению, при котором основное внимание уделяется сочетанию классической терапии с дополнительными средствами, способствующими укреплению организма и поддержанием его общего состояния.

РАК МОЧЕТОЧНИКА: ОТ ПРИЧИН ПОЯВЛЕНИЯ ДО МЕТОДОВ ЛЕЧЕНИЯ
Выбор клиники для лечения рака почки? Напишите нам — мы поможем с консультацией и подберем оптимальные варианты.








